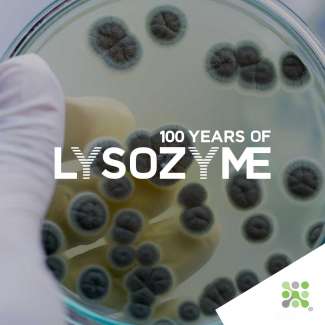

The first surviving records of the use of egg-white for its antibacterial and medicinal properties date back to ancient Greek and Roman societies. Dioscorides, the Greek physician, wrote in the 50-70 AD ‘De materia medica’ of egg-white as a medicinal salve for the eyes, a practice that has echoes across both ancient Roman, and traditional Sudanese practice also1.
blog
Exploring Natural Enzymes and Proteins
Welcome to the Bioseutica® Blog, your premier resource for comprehensive articles on natural enzymes and proteins. Dive into the science behind these essential components, extracted from natural sources like the pancreas and eggs. Discover their applications and the multitude of benefits they offer across various industries.
Unveiling the Science of Natural Enzymes
Our blog discusses extracting and utilizing key enzymes such as muramidase, hydrolase, and protease. Learn how these natural enzymes contribute to health, wellness, and industrial applications and why they are crucial for various processes.
The Power of Proteins from Natural Sources
Explore the fascinating world of proteins derived from natural sources. Understand how proteins extracted from the pancreas and eggs play a vital role in numerous biological and industrial functions. Our articles shed light on the methods and benefits of utilizing these natural proteins.
The Rich History of Bioseutica®
Delve into the intriguing history of Bioseutica®, tracing our origins and evolution. Learn about our journey from the beginning to becoming a leading global enzyme manufacturer. Discover the milestones and achievements that have shaped our commitment to quality and innovation.
Future Developments in Ingredients and Microbiology
Stay informed about the future developments in ingredients and microbiology at Bioseutica®. Our blog covers the latest advancements and research in the field, showcasing how we continue to push the boundaries of science and sustainability. Learn about our innovative approaches and the future of enzyme and protein solutions.
Why Choose Bioseutica®?
Bioseutica® is recognized as a top-tier enzyme manufacturer for the USA and China markets, specializing in producing essential enzymes. Our state-of-the-art production capabilities and stringent adherence to quality standards position us as a leader in the global enzyme market. Dedicated to innovation and sustainability, we provide enzyme solutions that are effective and environmentally friendly. Our services are designed to meet the diverse needs of industries across the globe, ensuring that no matter where you are, you can benefit from the highest quality of enzyme manufacturing available. Trust Bioseutica® to enhance your operations with our expertly crafted enzymatic solutions.
Explore our blog to learn more about natural enzymes and proteins, the history of Bioseutica®, and our commitment to future innovations in microbiology. Join us as we lead the way in quality, sustainability, and scientific excellence.
The first Italian Penicillin
24th May 1947 saw the establishment of SPA (Società Prodotti Antibiotici) by Pharmacologist Dr. Rodolfo Ferrari and microbiologist Carlo Callerio. Now Italy had its own domestic Penicillin, available in vials and tablets as SUPERCILLIN and PRONTOCILLIN.
Italy, 1947
We are in its second year as a Republic. The constituent assembly has written and voted to accept the new constitution, and President Alcide de Gasperi has formed a new government.
A nation’s entire supply of Penicillin
The death of their first trial patient through the insufficient supply of Penicillin drove Florey, Chain, and their research assistant Heatley forward with inspired momentum. Increasing production was an absolute necessity.
It is becoming ever more apparent that these key tools that modern medicine has come to rely upon are facing increasing risk to their efficacy. The UN General Assembly declared in 2016 that antibiotic resistance was the greatest and most urgent global threat, with a shocking 10,000,000 annual deaths projected by 2050 as a result of antimicrobial-resistant infections.
AVIDIN’s discovery came from the observation of dramatic biotin deficiency (Vitamin H, B7, or Co-enzyme R) in chicks fed a raw egg-white diet1. The conclusion made was that this ‘egg-white injury’ resulted from a component in the egg-white withholding Biotin from the chicks, a finding since repeated in organisms ranging from ants to rats2.
Father and Son Nobel Prize
This award is notable not only because it was the first and only time that a father-son duo has been awarded the Nobel but also because Lawrence was only 25 then. Indeed, he remained the youngest ever awardee until Malala Yousafzai’s (17) award for her work against the suppression of children’s education in 2014.
This gram-positive bacteria is particularly infamous for causing late blowing defects in cured, hard and semi-hard cheeses, dramatically reducing quality, rendering it entirely unmarketable. Cheese makers have been trusting Bioseutica’s® LYSOLAC® for over 30 years to naturally prevent late blowing, protecting their cheese and its commercial value.
Viticulture extends back to and coincides with the earliest settling of humans, ancient Persia being regarded as the first winemaking culture. From here (quite understandably), grape cultivation and winemaking spread, leaving traces across the southern Caucasus and into what is now Greece.
Methane emissions account for half of the 1oC rise in average global temperatures since the beginning of industrialisation. The considerable bright side is that methane is relatively short-lived in the atmosphere when compared to CO2, so interventions that reduce methane emissions will have a rapid impact.
Whereas the elegant cube-like structure of salt (NaCl) was met with what was essentially disbelieving anger, Francis Crick famously asked at the 1965 public presentation of Lysozyme’s structure, “Could that be where the substrate polysaccharide binds?”.
The story of its discovery by Alexander Fleming is one of serendipity. For Fleming, it was not the fall of an apple, but that of mucous landing in a bacterial culture that revealed the efficacy of Lysozyme in rupturing the cell wall of bacteria. It is this powerful bacteriolytic effect that led to its naming.